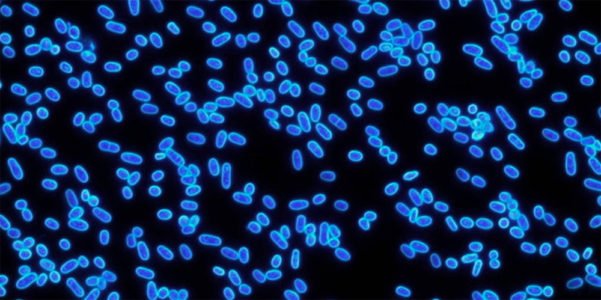

About Luca Tobagi
Investment Strategist
Invesco
Latest Articles
Guerra o Pace?
news
Oggi è una giornata difficile, triste perchè comincia una guerra con l’invasione dell’Ucraina da parte della Russia. Una guerra che……
Il ritorno delle pagelle
news
Chi ben comincia è a metà dell’opera. Il noto proverbio sembra particolarmente valido per i mercati azionari. Già quattro anni……
Il presidente Mattarella ha incaricato Mario Draghi di formare un nuovo governo. Già questo basta a rendere gli eventi di Febbraio 2021 memorabili.
news
Non ho mai pensato che, nel medio-lungo periodo, la politica avesse una grande rilevanza per l’andamento dei mercati finanziari. Né……
Diversificazione: utile per cogliere opportunità di rendimento nei momenti di svolta
news
Nel 2020, pur con qualche eccesso, gli investitori si sono comportati nel modo consueto. Innanzitutto, come ipotizzavo l’anno scorso, sono……
Non è una fine, solo un altro inizio
news
E così il 3 novembre è arrivato ed è passato. La democrazia statunitense sembra essere stata la vincitrice delle elezioni……
Valore a rischio e lavori in corso
news
Non è ciò che non sai a metterti nei guai. È quello che sai per certo e che invece non……
La biologia della politica economica
news
Quando ero al liceo, la biologia non mi piaceva molto. Del liceo classico amavo le materie umanistiche, soprattutto il greco,……
Inflazione e cambi di mentalità
news
Jeff Bezos, CEO e fondatore di Amazon.com, ha dichiarato: “Ci sono due tipi di aziende: quelle che lavorano per cercare……
Commento alle elezioni regionali di Emilia-Romagna e Calabria
news
Le elezioni regionali in Emilia-Romagna e Calabria hanno fornito agli investitori spunti interessanti. In Calabria abbiamo assistito alla vittoria di……
The happiness advantage: quando avere un atteggiamento positivo fa bene
news
Entriamo nel 2020 dopo un anno molto interessante, in cui i mercati finanziari hanno avuto rendimenti molto positivi, pur in……